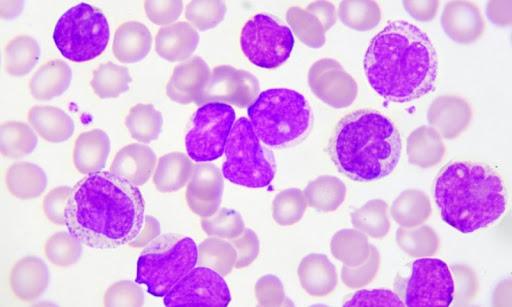

Λεμφοκυττάρωση είναι η αύξηση του αριθμού των λεμφοκυττάρων (πάνω από 4.000/μικρολίτρο) στο αίμα.
Τα λεμφοκύτταρα είναι τα βασικά κύτταρα του ανοσοποιητικού συστήματος, καθώς διαδραματίζουν σημαντικό ρόλο στην αντιμετώπιση των λοιμώξεων.
Αυξημένα λεμφοκύτταρα (λεμφοκυττάρωση) έχουμε σε οξείες ή χρόνιες ιογενείς λοιμώξεις σε λεμφοκυτταρικές λευχαιμίες και λεμφώματα.
Σύφιλη: Η σύφιλη είναι ένα σεξουαλικώς μεταδιδόμενο νόσημα που προσβάλλει άνδρες και γυναίκες και προκαλείται από το βακτήριο Treponema pallidum.
Μόλυνση ή λοίμωξη, που οφείλεται σε κάποιο βακτήριο.
Αυτοάνοση πάθηση, που προκαλεί αυξημένα επίπεδα φλεγμονής στον οργανισμό.
Τα αυξημένα λεμφοκύτταρα, μπορεί να αποτελούν ένδειξη αιματολογικού καρκίνου (λέμφωμα ή και λευχαιμία).
Λειτουργική διαταραχή του θυρεοειδούς κατά την οποία, ο αδένας λειτουργεί δυσανάλογα λιγότερο ή περισσότερο σε σχέση με τις ανάγκες του ατόμου.
Φυματίωση: Η φυματίωση είναι μια κοινή και σε πολλές περιπτώσεις, θανατηφόρα, μολυσματική νόσος, η οποία προκαλείται από διάφορα στελέχη μυκοβακτηρίων και προσβάλει συνήθως τον πνεύμονα και άλλα μέρη του σώματος.
Κοκκύτης: Ο κοκκύτης, επίσης γνωστός ως βήχας 100 – ημερών, είναι μία εξαιρετικά μεταδοτική βακτηριακή νόσος. Αρχικά, τα συμπτώματα είναι συνήθως παρόμοια με εκείνα του κοινού κρυολογήματος με ρινική καταρροή, πυρετό, και ήπιο βήχα.